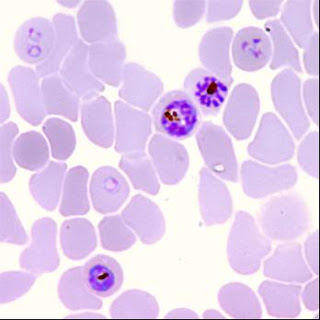

![]() |
| Différents stades de développement de Plasmodium falciparum dans les globules rouges. Source iconographique et légendaire: http://www2.cnrs.fr/en/1728.htm |
Primaquine dans la prévention de la transmission de la malaria due à
falciparum
La malaria due à falciparum est transmise par des moustiques anophèles qui,
dans le sang ingéré pour leur prise alimentaire, ont reçu des gamétocytes de Plasmodium falciparum. Dans les zones à
faible transmission de la malaria - où les infections symptomatiques
contribuent de manière substantielle à la transmission de la malaria -, l’utilisation
de médicaments gamétocytocides permet de réduire l’incidence de la malaria. Les
thérapies à base d’artémisinine fournissent de bons résultats et réduisent
considérablement le taux de portage gamétocytaire. La résistance à l’artémisinine
chez P falciparum permet de réduire l’activité gamétocytaire globale produisant
une pression sélective sur l’extension de ces parasites résistants. Les
composés à base de 8-aminoquinoline possèdent cette propriété gamétocytocide
unique ; et neutralisent rapidement les stades matures transmissibles de P
falciparum. L’addition d’une dose de primaquine aux régimes à base de d’artémisinine
pourrait aider à contrer l’extension de la résistance à l’artémisinine. Bien que
la primaquine soit communément recommandée dans le traitement des malarias
falciparum et vivax, les préoccupations relatives aux hémolyses provoquées par la prise de ce médicament en empêchent
fréquemment l’administration. Les quelques données cautionnant les effets de
blocage de la transmission dus à la primaquine et de son prédécesseur plasmoquine,
suggèrent que les doses plus basses que celles actuellement recommandées (0,50 –
0,75 mg par kg), offrant plus de sécurité, pourraient encore être efficaces. Prof
Nicholas J White FRS, in The Lancet Infectious Diseases, Early Online
Publication, 23 November 2012
Source: The Lancet Online /
Traduction et adaptation: NZ
Aucun commentaire:
Enregistrer un commentaire